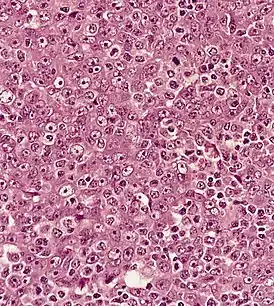

Назофарингеальная карцинома
Назофарингеальная карцинома (рак носоглотки) — злокачественная опухоль, развивающаяся в верхней части глотки и значительно отличающаяся от других типов опухолей головы и шеи по своему развитию, причинам, клиническому течению и лечебной тактике. Повышенная заболеваемость отмечена в некоторых регионах восточной Азии и Африки.
- база данных Disease ontology (англ.) — 2016.
| Назофарингеальная карцинома | |
|---|---|
| |
| МКБ-11 | 2B6B.0 |
| МКБ-10 | C11 |
| МКБ-10-КМ | C11, C11.9, C11.1, C11.2, C11.3 и C11.0 |
| МКБ-9 | 147 |
| МКБ-9-КМ | 147.9[1], 147.2[1], 147[1], 147.3[1], 147.1[1] и 147.0[1] |
| OMIM | 161550 |
| DiseasesDB | 8814 |
| eMedicine | ped/1553 |
| MeSH | D009303 |
This article is issued from Wikipedia. The text is licensed under Creative Commons - Attribution - Sharealike. Additional terms may apply for the media files.